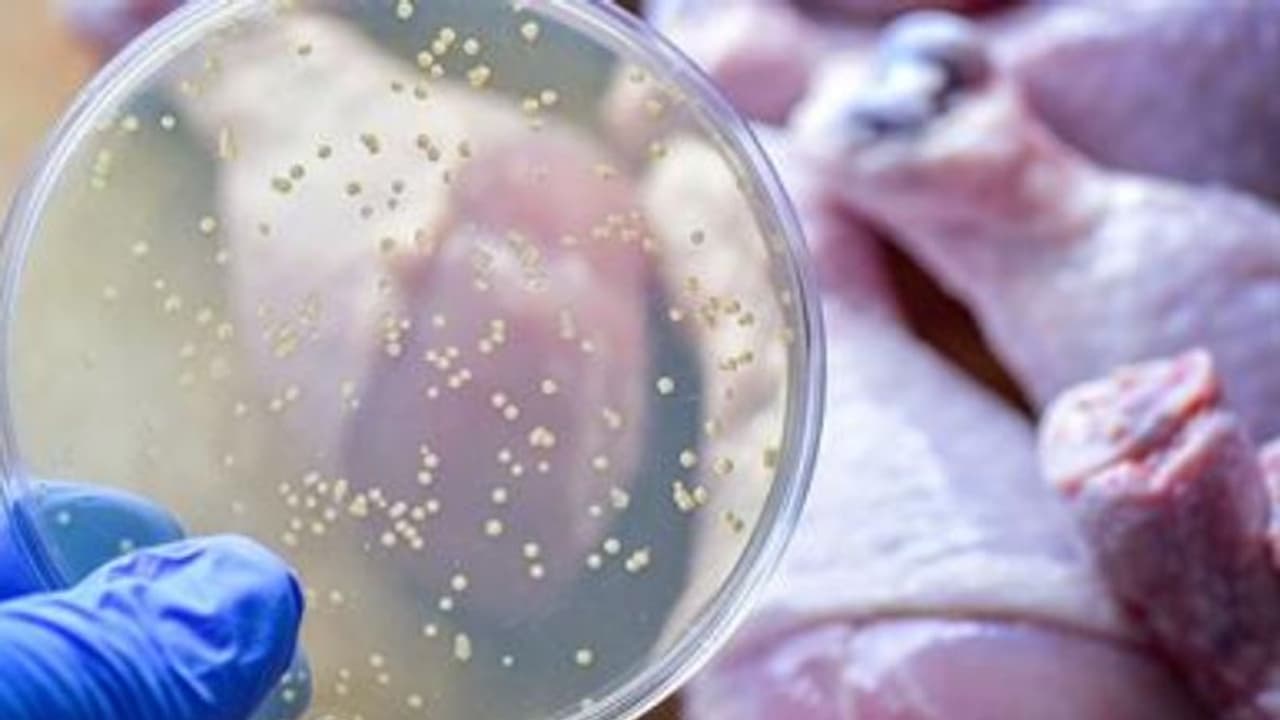
ഭക്ഷ്യവിഷബാധ ജീവനെടുക്കുമ്പോള്; ശ്രദ്ധിക്കേണ്ട ചില കാര്യങ്ങൾ... ഭക്ഷ്യവിഷബാധ ജീവനെടുക്കുമ്പോള്; ശ്രദ്ധിക്കേണ്ട ചില കാര്യങ്ങൾ...

ഭക്ഷണം ദീർഘനേരം അന്തരീക്ഷ ഊഷ്മാവിൽ വയ്ക്കുന്നത് നല്ലതല്ല. ആഹാരം ഉണ്ടാക്കിയ ശേഷം പെട്ടെന്ന് കഴിക്കണം. കൂടാതെ, സ്വാദ് കൂട്ടാൻ ഭക്ഷണത്തിൽ ഉപയോഗിക്കുന്ന പല രാസവസ്തുക്കളും വയറിന് അസ്വസ്ഥതയുണ്ടാക്കും.
അൽഫാമും കുഴിമന്തിയും കഴിച്ചതിനു പിന്നാലെ ഛർദിയും വയറിളക്കവും ബാധിച്ച് ഭക്ഷ്യവിഷബാധയേറ്റ് കോട്ടയത്ത് 33 കാരി മരിച്ച സംഭവം ഞെട്ടലോടെ ആണ് നാം കേട്ടത്. പലപ്പോഴും പുറത്തുനിന്നും വാങ്ങുന്ന പഴകിയതും വൃത്തിയില്ലാത്തതുമായ ആഹാരം കഴിക്കുമ്പോഴാണ് ഭക്ഷ്യവിഷബാധ പിടികൂടുന്നത്. ബാക്ടീരിയകൾ ഭക്ഷണത്തിനൊപ്പം ശരീരത്തിൽ പ്രവേശിച്ച് ശരിയായ ദഹനം നടക്കാതെ വരുന്നു. അത് പിന്നീട് ഛർദ്ദി, വയറിളക്കം, പനി, തലവേദന തുടങ്ങിയ പ്രശ്നങ്ങളുണ്ടാക്കുകയും ചെയ്യും.
ഭക്ഷണം ദീർഘനേരം അന്തരീക്ഷ ഊഷ്മാവിൽ വയ്ക്കുന്നത് നല്ലതല്ല. ആഹാരം ഉണ്ടാക്കിയ ശേഷം പെട്ടെന്ന് കഴിക്കണം. കൂടാതെ, സ്വാദ് കൂട്ടാൻ ഭക്ഷണത്തിൽ ഉപയോഗിക്കുന്ന പല രാസവസ്തുക്കളും വയറിന് അസ്വസ്ഥതയുണ്ടാക്കും. ഇത്തരത്തില് ഭക്ഷണത്തില് കലരുന്ന രാസവസ്തുക്കള് മൂലമോ ഭക്ഷണം പഴകുമ്പോഴുണ്ടാകുന്ന ബാക്ടീരിയയുടെ വളര്ച്ചമൂലമോ ഭക്ഷ്യവിഷബാധയുണ്ടാവാം.
ക്ലോസ്ട്രിഡിയം വിഭാഗത്തിലുള്ള ബാക്ടീരിയകളാണ് പ്രധാനമായും ഭക്ഷ്യവിഷബാധ ഉണ്ടാക്കുന്നത്. ഇത്തരം ബാക്ടീരിയകളുടെ സാന്നിധ്യമുള്ള ആഹാരം കഴിച്ച് ഏകദേശം പന്ത്രണ്ടുമണിക്കൂറിനുള്ളിൽ ലക്ഷണങ്ങൾ തുടങ്ങും.
ഭക്ഷണം കഴിച്ചശേഷമുണ്ടാകുന്ന ഓക്കാനം, കഠിനമായ വയറുവേദന, വയറിളക്കം, ഛർദ്ദി, തളർച്ച, തലവേദന, പനി എന്നി ലക്ഷണങ്ങൾ തുടക്കത്തിൽ തന്നെ ശ്രദ്ധിക്കണം. തുടർച്ചയായുള്ള ഛർദ്ദി, മലത്തിലൂടെയും ഛർദ്ദിയിലൂടെയും രക്തം പോവുക, മൂന്ന് ദിവസത്തിൽ കൂടുതലുള്ള വയറിളക്കം എന്നിവയ്ക്ക് ചികിത്സ നൽകേണ്ടതാണ്.
ഭക്ഷ്യവിഷബാധ എങ്ങനെ തടയാം?
- പഴകിയ ആഹാരം കഴിക്കരുത്.
- ഭക്ഷണം ദീർഘനേരം അന്തരീക്ഷ ഊഷ്മാവിൽ വയ്ക്കരുത്.
- കേടായ ഭക്ഷ്യവസ്തുക്കള് ഫ്രിഡ്ജില് സൂക്ഷിക്കരുത്.
- തണുത്ത ആഹാരം നന്നായി ചൂടാക്കി മാത്രം കഴിക്കുക.
- ഫ്രിഡ്ജിൽ നിന്നെടുത്ത ഭക്ഷണം ഒരിക്കൽ ചൂടാക്കിയ ശേഷം വീണ്ടും ഫ്രിഡ്ജിൽ വയ്ക്കരുത്.
- പായ്ക്കറ്റ് ഫുഡ് വാങ്ങുമ്പോൾ നല്ല ബാൻഡ് തിരഞ്ഞെടുക്കണം.
- കാലാവധി കഴിഞ്ഞ ആഹാര പദാര്ഥങ്ങള് ഉപയോഗിക്കരുത്.
- അടുക്കളയും പരിസരവും വൃത്തിയായി സൂക്ഷിക്കണം.
- കൈകള് സോപ്പുപയോഗിച്ച് വൃത്തിയായി കഴുകിയശേഷമേ ഭക്ഷണം പാചകം ചെയ്യാവൂ.
- ഭക്ഷണം വിളമ്പുന്ന പാത്രങ്ങള് വൃത്തിയുള്ളതായിരിക്കണം.
- യാത്രകളില് കഴിയുന്നതും സസ്യാഹാരം മാത്രം കഴിക്കുക.
Also Read: ശരീരത്തിന് വേണം 'വിറ്റാമിന് ഡി'; അറിയാം ഈ ഗുണങ്ങള്...